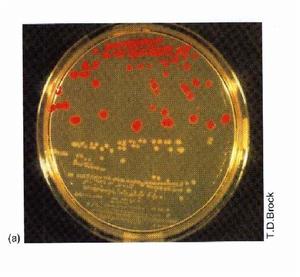
微生物生理學

概述
 微生物生理學
微生物生理學微生物生理學是微生物學的分支學科之一。它主要研究微生物的形態與發生、結構與功能、生長與繁殖、代謝與調等的作用機理節。
研究簡史
19世紀70年代以後,隨著人們對釀酒、動植物病害、人類疾病的防治和土壤微生物活 動等的研究,微生物生理學逐漸興盛起來。
 微生物生理學研究內容
微生物生理學研究內容1905年,A.哈登和W.J.楊發現磷酸鹽對酒精發酵的作用;1911年,C.諾伊貝格開始對酒精發酵作系統的研究;20世紀30年代,生物化學的進展(如O.邁爾霍夫、O.H.瓦爾堡和H.A.克雷布斯等人對發酵、呼吸、生物氧化機制的闡明)推動了人們對微生物代謝的研究。隨後,A.J.克勒伊沃和C.B.范尼爾等人又從比較生物化學的角度說明某些微生物的相互關係
和生理學問題。1933年,克勒伊沃建立了搖床培養技術,導致現代化微生物工業深層培養的生理研究和套用。同時,同位素、電子顯微鏡、超速離心、微量快速生物化學分析以及生物化學突變株等技術的普遍套用,也推動了微生物生理學研究的發展。
微生物種類繁多,生理類型複雜,就營養和能量轉換而論,既有像動物那樣異養生活的類群,也有像植物那樣進行光合作用的自養類群。另外還有利用化能的自養類群以及與其他生物具有共生或寄生關係的類群。在碳的同化方面,除一般的代謝類型外,微生物還有許多特殊的代謝途徑,可以產生有機酸、溶劑、脂肪酸、維生素、多糖等對人類有用的產物,也可產生氧化烴、芳香族化合物等,從而清除污染環境的物質。另外,微生物還可產生抗生素(見抗生素髮酵微生物)、色素、毒素、甾體化合物等次級代謝產物。氮的利用方面,微生物有能利用有機氮化合物的類群,也有能利用無機氮的類群。固氮菌、根瘤菌、藍細菌和某些異養菌能夠直接同化大氣中的氮。微生物的能量產生方式因好氧生活、厭氧生活或兼性生活而有所不同。光合細菌可通過光合磷酸化方式獲得能量,好氧菌可由氧化磷酸化獲得能量,厭氧菌可由底物水平的磷酸化獲得能量。在這些過程中,最終電子受體不是分子氧,而是硝酸鹽、硫酸鹽等。
研究方向
隨著分子生物學的發展,微生物生理學的研究不斷地向以下幾個方面深入:
細菌菌落
細菌菌落①細胞中的生物
化學轉化、能量的產生和轉換;
②生物大分子的結構與功能(核酸與蛋白質的合成、遺傳信息的傳遞以及膜的結構和功能等);
③ 分子水平上的形態建成、分化及其行為等。近年來,微生物生理學的研究擴展到了新的或過去不引人注意的微生物類群和可更新能源方面,這使人們對分解纖維素微生物和甲烷產生菌的生理進行深入的考察,並從化能自養菌的研究擴展到利用硫桿菌進行微生物浸礦。
另外,維生物與其他生物之間的共生、寄生關係是人們多年來一直注意的領域,尤其是共生固氮的研究已有較大的進展。能使石油氧化、農藥降解和人工合成的高分子物質分解的微生物,也越來越多地成為人們研究的對象。總之,每一新菌屬和新現象的發現(例如,在小球藻中發現了一種蛭弧菌),都為微生物生理學研究提供新的對象,開闢新的領域。
實驗
 水處理微生物照片
水處理微生物照片在大自然中,生活著一大類人的肉眼看不見的微小生命。無論是繁華的現代城市、富饒的廣闊田野、還是人跡罕見的高山之巔、遼闊的海洋深處,到處都有它們的蹤跡。這一大類微小的居民稱為微生物,它們和動物、植物共同組成生物大軍,使大自然顯得生機勃勃。
微生物檢驗中常用的生化反應有:
1、糖酵解試驗
不同微生物分解利用糖類的能力有很大差異,或能利用或不能利用,能利用者,或產氣或不產氣。可用指示劑及發酵管檢驗。
2、澱粉水解試驗
某些細菌可以產生分解澱粉的酶,把澱粉水解為麥芽糖或葡萄糖。澱粉水解後,遇碘不再變藍色。澱粉水解系逐步進行的過程,因而試驗結果與菌種產生澱粉酶的能力、培養時間,培養基含有澱粉量和pH等均有一定關係。培養基pH必須為中性或微酸性,以pH7.2最適。澱粉瓊脂平板不宜保存於冰櫃,因而以臨用時製備為妥。
3、V-P試驗
某些細菌在葡萄糖蛋白腖水培養基中能分解葡萄糖產生丙酮酸,丙酮酸縮合,脫羧成乙醯甲基甲醇,後者在強鹼環境下,被空氣中氧氧化為二乙醯,二乙醯與蛋白腖中的胍基生成紅色化合物,稱V-P(+)反應。
鑑定技術
形態結構和培養特性觀察
 相關書籍
相關書籍1、微生物的形態結構觀察主要是通過染色,在顯微鏡下對其形狀、大小、排列方式、細胞結構(包括細胞壁、細胞膜、細胞核、鞭毛、芽孢等)及染色特性進行觀察,直觀地了解細菌在形態結構上特性,根據不同微生物在形態結構上的不同達到區別、鑑定微生物的目的。
2、細菌細胞在固體培養基表面形成的細胞群體叫菌落(colony)。不同微生物在某種培養基中生長繁殖,所形成的菌落特徵有很大差異,而同一種的細菌在一定條件下,培養特徵卻有一定穩定性。,以此可以對不同微生物加以區別鑑定。因此,微生物培養特性的觀察也是微生物檢驗鑑別中的一項重要內容。
1)細菌的培養特徵包括以下內容:在固體培養基上,觀察菌落大小、形態、顏色(色素是水溶性還是脂溶性)、光澤度、透明度、質地、隆起形狀、邊緣特徵及遷移性等。在液體培養中的表面生長情況(菌膜、環)混濁度及沉澱等。半固體培養基穿刺接種觀察運動、擴散情況。
2)黴菌酵母菌的培養特徵:大多數酵母菌沒有絲狀體,在固體培養基上形成的菌落和細菌的很相似,只是比細菌菌落大且厚。液體培養也和細菌相似,有均勻生長、沉澱或在液面形成菌膜。黴菌有分支的絲狀體,菌絲粗長,在條件適宜的培養基里,菌絲無限伸長沿培養基表面蔓延。黴菌的基內菌絲、氣生菌絲和孢子絲都常帶有不同顏色,因而菌落邊緣和中心,正面和背面顏色常常不同,如青黴菌:孢子青綠色,氣生菌絲無色,基內菌絲褐色。黴菌在固體培養表面形成絮狀、絨毛狀和蜘蛛網狀菌落。
區別
 相關書籍
相關書籍微生物生理學是微生物學的分支學科之一。它主要研究微生物的形態與發生、結構與功能、生長與繁殖、代謝與 調等的作用機理節。微生物遺傳學是以病毒、細菌、小型真菌以及單細胞動植物等微生物為研究對象的遺傳學分支學科。微生物有個體小、生活周期短、能在簡單的合成培養基上迅速繁殖等特點,並且可以在相同條件下處理大量個體,所以是進行遺傳學研究的良好材料。
土壤微生物學主要研究土壤中微生物的種類、數量、分布、生命活動規律及其與土壤中的物質和能量轉化、土壤肥力、植物生長等的關係。 土壤微生物學不僅是微生物學的分支學科,也是土壤學的一個組成部分,而且與生物化學、農業化學、植物生理學和植物病理學等學科相互滲透。它的基本任務是發展土壤肥力和增強植物營養。微生物遺傳學的研究一方面要依靠生物化學的知識和方法,另一方面也對生物化學有許多貢獻。胺基酸、核苷酸及蛋白質和核酸等大分子的生物合成的研究多採用微生物為材料,而且常用微生物遺傳學方法。分子遺傳學是在微生物遺傳學的基礎上發展起來的一個遺傳學分支。遺傳密碼、轉錄、翻譯、信使核糖核酸、轉移核糖核酸等都是在微生物中被發現或證實的。
相關學科
生物學、植物學、孢粉學、動物學、微生物學、細胞生物學、分子生物學、生物分類學、習性學、生理學、細菌學、微生物遺傳學、土壤微生物學、細胞學、細胞化學、細胞遺傳學、免疫學、胚胎學、優生學、悉生生物學、遺傳學、分子遺傳學、生態學、仿生學、生物物理學、生物力學、生物力能學、生物聲學、生物化學、生物數學。
微生物學辭彙
| 微生物學(microbiology)生物學的分支學科之一。它是在分子、細胞或群體水平上研究各類微小生物(細菌、放線菌、真菌、病毒、立克次氏體、支原體、衣原體、螺鏇體原生動物以及單細胞藻類)的形態結構、生長繁殖、生理代謝、遺傳變異、生態分布和分類進化等生命活動的基本規律,並將其套用於工業發酵、醫學衛生和生物工程等領域的科學。 |
